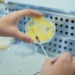

La Ciudad de València, Capital Europea del Turismo Inteligente 2022, va a acoger del 21 al 23 de noviembre el III Congreso Mundial de Destinos Inteligentes, convirtiéndose de esta forma en la sede del debate y del análisis de los retos y las nuevas propuestas en torno al modelo turístico mundial. Un evento organizado por el Ayuntamiento de València en colaboración con el Gobierno de España, la Generalitat Valenciana y la Organización Mundial del Turismo.
El objetivo es liderar y construir el nuevo modelo turístico del siglo XXI. Para ello, más de 60 expertos nacionales e internacionales, que representan a territorios que ya son destinos inteligentes, además de otros que destacan por sus buenas prácticas, compartirán conocimientos para profundizar en los cinco ejes que conforman un destino turístico inteligente: gobernanza, sostenibilidad, innovación, accesibilidad y tecnología. El evento contará con representantes de más de doce países entre los que se incluyen: Portugal, Países Bajos, Brasil, Cuba, Colombia, Jordania, Francia, Suecia, Finlandia, Perú y Reino Unido.
Durante la presentación, la vicealcaldesa y concejala de Desarrollo Urbano, Sandra Gómez, que ha estado acompañada del concejal de Turismo, Emiliano García y el director de Visit València, Antoni Bernabé, ha recordado que “la Capitalidad Europea del Turismo Inteligente que ostenta València es un reconocimiento de la UE al trabajo ya realizado”, y ha destacado que “acogemos este III Congreso Mundial de Destinos Inteligentes desde la experiencia, porque València ya tiene implantado el modelo de turismo que exige Europa. Un modelo que también reclama la sociedad, y que se caracteriza por la sostenibilidad, por el equilibrio de las necesidades de todos los que forman parte de esta actividad: desde el sector empresarial a los vecinos y residentes; salvaguardando el patrimonio cultural y natural, así como la autenticidad del propio destino”.
Por su parte, Emiliano García, ha apuntado el hecho de que este congreso “nos da la oportunidad de mostrar todos aquellos proyectos que estamos liderando desde la ciudad, como el Sistema de Inteligencia Turística, por ejemplo, o los proyectos desarrollados en materia hídrica, la posibilidad de absorción de emisiones que ofrece la huerta o el cálculo y posterior auditoría que deja la huella de carbono a partir de la actividad turística”.
Antoni Bernabé ha remarcado la importancia de la sostenibilidad como eje transformador del turismo y ha destacado en cifras lo que va a suponer este congreso: “más de 1.100 inscritos, que provienen de 45 países diferentes; más de 241 representantes institucionales; más de 80 ponentes repartidos entre empresas privadas y organizaciones públicas. Además se van a exponer más de 40 trabajos de investigación y contaremos con la presencia de más de 20 periodistas internacionales. Todo ello, da muestra del volumen y magnitud de un congreso que contará con stands experienciales para presentar como València lidera la gestión turística”
Una de las principales atracciones e innovaciones que se van a presentar en este evento va a ser la oficina de información turística en el metaverso, que tal y como ha explicado Gómez “nos va a permitir vivir una experiencia, con unas gafas de realidad virtual 3D, que consiste en entrar en una oficina de información turística en la que un avatar nos va a dar un asesoramiento personalizado de este destino turístico”.
Antoni Bernabé ha destacado el esfuerzo que se está haciendo desde el Ayuntamiento “por recrear el modelo de interacción e información con el turista”, y ha anunciado que “en este congreso también vamos a recrear el nuevo modelo de oficina de turismo que queremos implementar, sin mostradores ni barreras arquitectónicas, pero con herramientas interactivas que puedan mejorar la experiencia de los clientes”